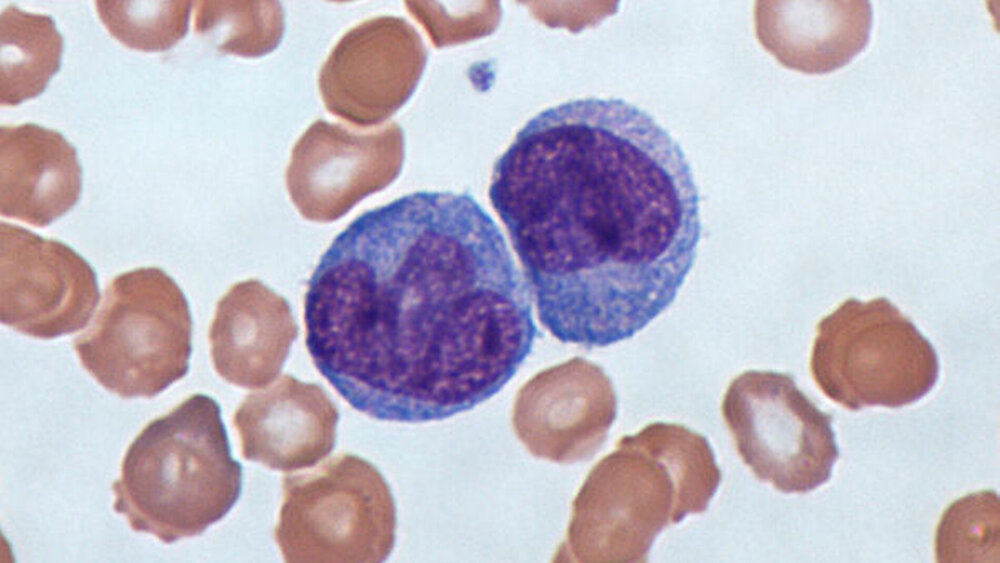

Unreife Zellen hemmen bei schweren Verläufen die Immunreaktion
Bei schweren Krankheitsverläufen von COVID-19 kommt es, anders als bislang allgemein angenommen, nicht allein zu einer starken Immunreaktion – vielmehr ist die Immunantwort in einer Dauerschleife aus Aktivierung und Hemmung gefangen. Fachleute der Charité Berlin, der Universität Bonn, des Deutschen Zentrums für Neurodegenerative Erkrankungen (DZNE), des Helmholtz-Zentrums für Infektionsforschung (HZI) und des Deutschen Zentrums für Infektionsforschung (DZIF) präsentieren diese Befunde im Wissenschaftsjournal Cell.
„Man weiß noch immer wenig über die Ursachen dieser schweren Verläufe. Die hohen Entzündungswerte, die man bei den Betroffenen misst, sprechen eigentlich für eine starke Immunantwort. Klinische Befunde sprechen aber eher für eine ineffektive Immunantwort. Hier gibt es einen Widerspruch“, sagt Prof. Dr. Joachim Schultze von der Universität Bonn, der auch Forschungsgruppenleiter am DZNE ist. „Wir vermuteten daher, dass Immunzellen zwar in großer Menge produziert werden, sie jedoch in ihrer Funktion gestört sind." Deshalb haben wir das Blut von Patientinnen und Patienten mit unterschiedlicher Krankheitsschwere von COVID-19 untersucht“, berichtet Prof. Dr. Leif Erik Sander von der Medizinischen Klinik mit Schwerpunkt Infektiologie und Pneumologie der Charité.
Studie untersuchte zunächst die Eigenschaften der Immunzellen
Die Blutproben stammten von insgesamt 53 Männern und Frauen mit COVID-19 aus Berlin und Bonn, deren Krankheitsverlauf gemäß der Klassifikation der Weltgesundheitsorganisation in mild oder schwer eingeteilt wurde. Als wichtige Vergleichsgröße dienten Blutproben von Personen mit anderen viralen Atemwegsinfekten sowie von gesunden Personen. Für die Untersuchungen kamen unter anderem Single-Cell-OMICs-Technologien zum Einsatz: ein Sammelbegriff für moderne Messverfahren, mit denen sich beispielsweise die Genaktivität und das Aufkommen von Eiweißstoffen für einzelne Zellen – und somit sehr präzise – bestimmen lassen. Anhand dieser Daten charakterisierten die Forschenden die Eigenschaften von im Blut zirkulierenden Immunzellen.
„Diese äußerst umfangreiche Datenerhebung der Genaktivität jeder einzelnen Zelle ermöglichte es uns, mit bioinformatischen Methoden einen umfassenden Blick auf die laufenden Prozesse in den weißen Blutkörperchen zu gewinnen“, erklärt Prof. Dr. Yang Li vom Zentrum für Individualisierte Infektionsmedizin (CiiM) und vom Helmholtz-Zentrum für Infektionsforschung (HZI) in Hannover. In Kombination mit der Betrachtung von wichtigen Eiweißmolekülen auf der Oberfläche von Immunzellen konnten die Wissenschaftler so die Veränderungen im Immunsystem von Patientinnen und Patienten mit COVID-19 entschlüsseln.
Myeloide Zellen haben eine Schlüsselposition
Das menschliche Immunsystem umfasst ein breites Arsenal von Zellen und anderen Verteidigungsmechanismen, die sich gegenseitig beeinflussen. In der aktuellen Studie lag der Fokus auf sogenannten myeloiden Zellen, zu denen auch Neutrophile und Monozyten gehören. Das sind Immunzellen, die in der Reaktionskette der Immunantwort recht weit vorne stehen, also sehr früh zur Abwehr von Infektionen mobilisiert werden. Sie beeinflussen zudem die spätere Bildung von Antikörpern und anderen Zellen, die zur Immunität beitragen. Dadurch kommt den myeloiden Zellen eine Schlüsselposition zu.
„Wir haben bei den sogenannten Neutrophilen und den Monozyten festgestellt, dass diese Immunzellen bei milden Krankheitsverläufen von COVID-19 aktiviert, also abwehrbereit sind. Sie sind auch so programmiert, dass sie den Rest des Immunsystems in Gang setzen. So kommt es letztlich zu einer ausreichenden Immunantwort gegen das Virus“, erklärt Dr. Antoine-Emmanuel Saliba vom Helmholtz-Institut für RNA-basierte Infektionsforschung (HIRI) in Würzburg.
Funktion der Neutrophile und Monozyten ist gestört
Anders ist die Situation bei den schweren Fällen von COVID-19, wie Prof. Sawitzki erläutert: „Hier sind Neutrophile und Monozyten zwar zum Teil aktiviert, aber auch in ihrer Funktion gestört. Wir finden deutlich mehr unreife Zellen, die eher hemmend auf die Immunreaktion wirken.“ Prof. Sander ergänzt: „Das Phänomen lässt sich auch bei anderen schweren Infektionen beobachten, der Grund dafür ist jedoch unklar. Es spricht vieles dafür, dass sich das Immunsystem bei schweren COVID-19-Verläufen gewissermaßen selbst im Wege steht. Dadurch kommt es womöglich zu einer unzureichenden Immunantwort gegen das Coronavirus, bei gleichzeitiger starker Entzündung im Lungengewebe.“
Die aktuellen Befunde könnten auf neue Therapiemöglichkeiten hindeuten, meint Dr. Anna Aschenbrenner vom LIMES Institut der Universität Bonn: „Unsere Daten legen nahe, dass man bei schweren Krankheitsverläufen von COVID-19 Strategien erwägen sollte, die über die Behandlung anderer Viruserkrankungen hinausgehen.“ Eigentlich wolle man bei viralen Infekten das Immunsystem nicht unterdrücken, meint die Bonner Forscherin. „Wenn jedoch zu viele dysfunktionale Immunzellen auftreten, wie es unsere Studie zeigt, dann möchte man solche Zellen sehr wohl unterdrücken oder umprogrammieren.“
Neuer Therapieansatz: Präparate, die auf das Immunsystem einwirken, sollen helfen
Prof. Dr. Jacob Nattermann von der Medizinischen Klinik I des Universitätsklinikums Bonn, der auch Arbeitsgruppenleiter im DZIF ist, erläutert weiter: „Medikamente, die auf das Immunsystem einwirken, könnten vielleicht weiterhelfen. Das ist allerdings ein Balance-Akt. Denn es geht darum, das Immunsystem nicht gänzlich herunterzufahren, sondern nur jene Bereiche, die sich sozusagen selbst ausbremsen. Das sind in diesem Fall die unreifen Zellen. Möglicherweise können wir von der Krebsforschung lernen. Hier gibt es Erfahrung mit Therapien, die bei solchen Zellen ansetzen.“
Angesichts der vielen Beteiligten betont Prof. Schultze die Zusammenarbeit innerhalb des Forschungskonsortiums: „Diese Studie ist nach unserem Wissen eine der bislang umfangreichsten zur Immunantwort bei COVID-19 auf der Grundlage von Einzelzell-Daten. Die parallele Auswertung zweier unabhängiger Patientenkohorten ist eine der Stärken unserer Studie. Wir haben Patientengruppen von zwei unterschiedlichen Standorten mit verschiedenen Methoden analysiert und konnten so unsere Befunde direkt validieren. Das ist nur möglich, wenn Forschungsdaten offen geteilt werden und man vertrauensvoll kooperiert. Dies ist gerade in der aktuellen Krisensituation enorm wichtig.“
Schulte-Schrepping J et al. "Severe COVID-19 is marked by a dysregulated myeloid cell compartment". Cell (2020).doi: 10.1016/j.cell.2020.08.001